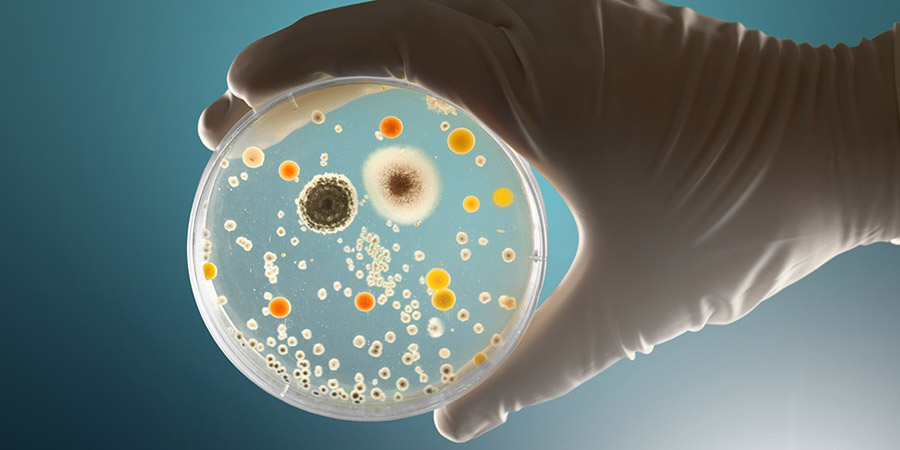

ความชื้นในอากาศมีความสัมพันธ์โดยตรงกับการเจริญเติบโตเชื้อโรค

ความชื้นในอากาศมีความสัมพันธ์โดยตรงกับการเจริญเติบโตและการกระจายของเชื้อโรคหลายประเภท โดยเฉพาะเชื้อแบคทีเรียและเชื้อรา นี่คือรายละเอียดเกี่ยวกับความสัมพันธ์นี้:

เชื้อแบคทีเรีย:
แบคทีเรียหลายชนิดชอบสภาพแวดล้อมที่มีความชื้นสูง เนื่องจากความชื้นช่วยให้แบคทีเรียสามารถเติบโตและขยายพันธุ์ได้ดีขึ้น ตัวอย่างเช่น เชื้อโรคที่ทำให้เกิดโรคทางเดินหายใจ เช่น Mycobacterium tuberculosis (วัณโรค) หรือ Streptococcus pneumoniae (ปอดบวม) อาจแพร่กระจายได้ง่ายขึ้นในอากาศที่มีความชื้นสูง
นอกจากนี้ ความชื้นสูงในสภาพแวดล้อมสามารถทำให้เสื้อผ้าและสิ่งของต่างๆ เปียกน้ำ ซึ่งอาจเป็นแหล่งเพาะพันธุ์ของแบคทีเรียและเชื้อราได้
เชื้อรา (Fungi):
เชื้อรามักเจริญเติบโตในที่มีความชื้นสูง เช่น ในบริเวณที่มีการรั่วซึมของน้ำหรือในสถานที่ที่มีการระบายอากาศไม่ดี เช่น ห้องน้ำและห้องใต้ดิน
เชื้อราที่พบได้ทั่วไป เช่น Aspergillus และ Penicillium ซึ่งสามารถก่อให้เกิดโรคทางเดินหายใจและโรคผิวหนังได้ โดยเฉพาะในผู้ที่มีภูมิคุ้มกันอ่อนแอ
ไวรัส:
ความชื้นยังมีผลต่อการอยู่รอดและการแพร่กระจายของไวรัส เช่น ไวรัสไข้หวัดใหญ่ และ ไวรัสโคโรนา ที่สามารถแพร่กระจายได้ดีในสภาพแวดล้อมที่มีความชื้น
การศึกษาพบว่า ไวรัสบางชนิดจะอยู่รอดได้นานขึ้นในอากาศที่มีความชื้นสูง แต่ก็อาจแพร่กระจายได้เร็วขึ้นเมื่อมีความชื้นต่ำในบางกรณี
ผลกระทบจากอุณหภูมิและความชื้น:
อุณหภูมิและความชื้นที่สูงอาจเพิ่มความสามารถในการแพร่กระจายของเชื้อโรคในอากาศ ขณะที่ความชื้นต่ำอาจช่วยลดการแพร่กระจายของเชื้อโรคบางชนิด เช่น เชื้อไวรัสบางชนิดอาจลดความสามารถในการติดเชื้อเมื่อมีความชื้นต่ำ
โดยรวมแล้ว ความชื้นสูงช่วยให้เชื้อโรคหลายชนิดเจริญเติบโตได้ดีขึ้น ซึ่งอาจส่งผลต่อการแพร่ระบาดของโรคได้ง่ายขึ้นในสภาพแวดล้อมที่มีความชื้นสูง.
ตารางด้านล่างแสดงช่วงของความชื้นที่เหมาะสมต่อการเติบโตของเชื้อโรคบางชนิด ซึ่งแสดงให้เห็นถึงความสัมพันธ์ระหว่างความชื้นกับการเจริญเติบโตของเชื้อแบคทีเรีย เชื้อรา และไวรัส:

หมายเหตุ:
ความชื้นสูง (มากกว่า 70%) สามารถช่วยเพิ่มการเจริญเติบโตของเชื้อราและแบคทีเรียหลายชนิด เนื่องจากมันช่วยให้แหล่งน้ำในสิ่งแวดล้อมมีความพร้อมสำหรับการเจริญเติบโตของเชื้อโรค
ในทางกลับกัน ความชื้นต่ำ จะลดการเติบโตของบางเชื้อโรค แต่ไม่ใช่ทุกกรณี โดยไวรัสบางชนิดสามารถแพร่กระจายได้ง่ายขึ้นในความชื้นต่ำ เช่น ไวรัสไข้หวัดใหญ่ที่อาจแพร่กระจายได้ดีในอากาศแห้ง
ข้อมูลอ้างอิง:
องค์การอนามัยโลก (WHO): คู่มือเกี่ยวกับคุณภาพอากาศภายในอาคารของ WHO ซึ่งกล่าวถึงความชื้นและสุขภาพโดยเฉพาะ
ศูนย์ควบคุมและป้องกันโรคแห่งสหรัฐอเมริกา (CDC): รายงานเกี่ยวกับการควบคุมเชื้อราและแบคทีเรียภายในบ้านและสถานที่ทำงาน
วารสารสุขอนามัยสิ่งแวดล้อมและอาชีวอนามัย (Journal of Environmental Health) และ วารสารการวิจัยทางการแพทย์ (Journal of Medical Microbiology): บทความเกี่ยวกับผลกระทบของความชื้นต่อการเจริญเติบโตของเชื้อโรค
American Society of Heating, Refrigerating, and Air-Conditioning Engineers (ASHRAE): เอกสารแนวทางเรื่องการควบคุมสภาพอากาศในอาคาร ซึ่งครอบคลุมถึงระดับความชื้นที่เหมาะสมเพื่อสุขภาพ


